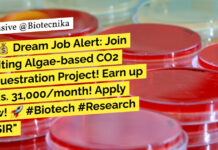
CSIR-CSMCRI Biotech, Microbiology Project Associate Recruitment - Applications Invited

Home 2024
Yearly Archives: 2024
Biotechnology Healthcare Research Analyst Opportunity at Clarivate – Apply Now
Biotechnology Healthcare Research Analyst Opportunity at Clarivate - Apply Now
Healthcare Research & Data Analyst
Location: Karnataka, India
Category: Life Sciences & Healthcare
Remote: Hybrid...
Executive Quality Assurance Job at iD Fresh Food! BSc Food Science, Food Tech Apply
Executive QA Job at iD Fresh Food! BSc Food Science, Food Tech Apply
Executive - Supplier Quality Assurance Anekal, Karnataka, India
About the job About iD...
Clinical Document Specialist Job at Novotech – Apply Online Now
Clinical Document Specialist Job at Novotech - Apply Online Now
Clinical Document Specialist
India
JOB DESCRIPTION
Brief Position Description:
The Clinical Document Specialist (CDS) will provide support for Trial...
Cytiva Life Science Associate Scientist Job Opening – Apply Online
Cytiva Life Science Associate Scientist Job Opening - Apply Online
Fast Trak Associate Scientist - Upstream
Cytiva Bangalore, Karnataka, India
Category: Science
Job Id: R1267665
Location: Bangalore, Karnataka, India
The...
Freshers Life Science Job Opening at Thermo Fisher – Apply For Scientist Role
Freshers Life Science Job Opening at Thermo Fisher - Apply For Scientist Role
Scientist I, Molecular Biology
Location: Bangalore, Karnataka, India
Job Id: R-01262195
Job Type: Full time
Category:...
Biotecnika Times Newsletter 11.07.2024 – 25+ Bioinformatics Project Jobs at BRIC-ILS, BIRAC High Pay...
25+ Bioinformatics, Mol Bio, Life Sciences Project Vacancies at BRIC-ILS With upto Rs. 67,000 pm Pay - Apply Online
Institute of Life Sciences (ILS) invites...
CSIR-CSMCRI Biotech, Microbiology Project Associate Recruitment – Applications Invited
CSIR-CSMCRI Biotech, Microbiology Project Associate Recruitment - Applications Invited
ONLINE INTERVIEW
Applications are invited for Project Associate -I (PA-I) to work in the research project entitled...
ICGEB Delhi MSc Life & Plant Science Research Fellow Job – Applications Invited
ICGEB Delhi MSc Life & Plant Science Research Fellow Job - Applications Invited
VACANCY NOTICE for Senior Research Fellow
Applications are invited for the post of...
Amity Institute of Pharmacy Life Sciences & Biotech Research Fellow Job Opening – Apply...
Amity Institute of Pharmacy Life Sciences & Biotech Research Fellow Job Opening - Apply Online
Advertisement Date: 11.07.2024
Amity University Uttar Pradesh, Noida invites applications for
Amity...
CSIR-CDRI Biotech, Biological & Life Sciences Non-NET Project Staff Positions – Apply Online
CSIR-CDRI Biotech Jobs, Biological & Life Sciences Non-NET Project Staff Positions - Apply Online
CSIR-CDRI Biotech Jobs, Biological & Life Sciences Non-NET Project Staff Positions...
Syngene Associate Scientist Job For BTech & MTech Biotechnology, Apply Online
Syngene Associate Scientist Job For BTech & MTech Biotechnology, Apply Online
Title: Associate Scientist MSAT
Date: 11 Jul 2024
Job Location: Bangalore
Pay Grade: 8-I
Year of Experience: 3...
25+ Bioinformatics, Mol Bio, Life Sciences Project Vacancies at BRIC-ILS With upto Rs. 67,000...
ILS Project Vacancies 2024 - Bioinformatics, Life Sciences Apply Online
ILS Project Vacancies 2024 - Bioinformatics, Life Sciences Apply Online. Interested and eligible applicants can...
IISER Tirupati MSc Biology Project Associate Job Opening – Apply Now
IISER Tirupati MSc Biology Project Associate Job Opening - Apply Now
Advertisement No.: 45/2024
Recruitment for the posts of “Project Associate- I under DBT India Alliance/...
Medpace Clinical Research Associate Entry Job – BSc Life Sciences Apply Online
Medpace Clinical Research Associate Entry Job - BSc Life Sciences Apply Online
Clinical Research Associate Entry
Navi Mumbai, India
Clinical Monitoring
10129
Job Summary
Our successful Clinical Research Associates possess...
Promea QA Executive Job For Biotech & Biology – Apply Online
Promea QA Executive Job For Biotech & Biology - Apply Online
Quality Assurance (Biologics) - Executive
FULL-TIME
HYDERABAD
1-5 YRS
Quality Assurance - Executive
We are seeking an Executive to...